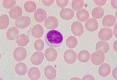
Lymphocyte
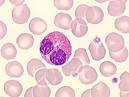
pe
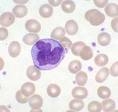
Monocyte

Le sang : définition, composition et éléments figurés
Ecole de Formation ParaMédicale de Tiaret (EFPM)
Laborantin Diplomé d’Etat
L’utilité des analyses médicales pour le diagnostic des anemies
par
Djamel AICHE
2010
L’hématologie est une spécialité de la médecine qui est chargée d’étudier le sang el pathologies qui s’y rapportent.
En hématologie, on insiste sur les cellules sanguines qui sont très important pour le bon fonctionnement du corps humain. Cette science étudie aussi certaines molécules plasmatiques.
Les maladies hématologiques sont appelées hémopathies et elles sont nombreuses, les plus connues sont les leucémies, les hémophilies ou l’anémie qui est un problème de santé publique fréquent dans le monde.
Elle comporte des graves conséquences pour la santé et le bien être ainsi que des répercussions sociales et économiques.
Pour cette raison, le laborantin diplômé d’Etat doit capable de reconnaître les différents types d’anémie et leurs diagnostic différentiel.
On peut classer les anémies de plusieurs façons, une classification d’un point de vu physiologique d’une part, à savoir les anémies dues à une baisse de production de globules rouges, et d’autres part les anémies dues à un hémolyse.
Les conséquences de l’anémie sont multiples et variées et peuvent être diagnostiquées par une démarche des analyses biologiques.
Or durant notre stage pratique à plein temps et cursus de formation au niveau des laboratoires de l’EPH et l’EPSP de Bordj-Bounaàma, certains problèmes ont été recensés ayant un impact négatif sur l’activité dont il serait nécessaire de les énumérer à savoir :
- Le personnel prestataire insuffisant (laborantin).
- Moyens matériels insuffisants.
- Ruptures fréquentes et répétées en réactifs et produits de diagnostic obligeant les malades à s’orienter vers les laboratoires privés.
- Nombre élevé de malades.
Ce qui nous a poussé et suscité à poser des interrogations:
N’ont-elles pas un impact pour le diagnostic des anémies ?
Quels sont les motifs qui empêchent le diagnostic pour ce faire ?
L’amélioration de la situation doit être réalisée par:
Le renforcement des laboratoires en moyens humains par le recrutement des laborantins diplômés d’état avec l’amélioration des connaissances.
Dotation des laboratoires en réactifs et matériels nécessaires.
Notre objectif consiste à faire une étude pratique sur le terrain à fin de faire ressortir les anomalies et de proposer les solutions pour améliorer la situation.
Durant mon cursus pédagogique en qualité d’élève laborantin diplômé d’état au niveau de l’école paramédicale de Tiaret, et à l’issue des trois années de formation et en vue de la réalisation d’un mémoire de fin d’études, mon choix a porté un thème relatif aux anémies toutes formes confondues.
Compte tenu des difficultés constatées sur les terrains ayant fait au diagnostic biologique de ces dernières, ce qui une permettra de le développer des éclaircissements espérant que ce modeste travail sera considéré comme outil et contribuer d’une manière ou autres à l’amélioration des prestations.
Le sang
Définition du sang
Le sang est un tissu conjonctif liquide formé de populations cellulaires libres, dont le plasma est la substance fondamentale et est présent chez la plupart des animaux.
Un humain adulte est doté d’environ 5 litres de sang.
Ce liquide sert à diffuser le dioxygène (O2) et les éléments nutritifs nécessaires aux processus vitaux de tous les tissus du corps, et à transporter les déchets tels que le dioxyde de carbone (CO2) ou les déchets azotés vers les sites d’évacuation (intestins, reins, poumons).
Il sert également à amener aux tissus les cellules et les molécules du système immunitaire, et à diffuser les hormones dans tout l’organisme.
C’est la moelle osseuse qui produit les cellules sanguines au cours d’un processus appelé hématopoïèse.
En tant que tissu conjonctif, le sang contient des éléments cellulaires et des substances fondamentales, mais il est dépourvu de fibres.
La couleur rouge du sang vient de l’hémoglobine.
Eléments figurés
Elles ne possèdent ni noyau ni organites, donc ne sont pas des cellules proprement dites.
Elles contiennent l’hémoglobine (1⁄3 des composants du cytoplasme) qui permet de fixer l’oxygène mais aussi le dioxyde de carbone ou le monoxyde de carbone.
Leur durée de vie est de 120 jours et leur destruction est opérée par le foie, la rate ou la moelle osseuse.
Qui servent dans le système immunitaire à détruire les agents infectieux. Les leucocytes sont un ensemble hétéroclite de cellules :
- Les granulocytes ou polynucléaires (neutrophiles, éosinophiles, basophiles);
- Les lymphocytes et les monocytes.
Thrombocytes: ou plaquettes (0,6 – 1,0 %)
Responsables de la formation du clou plaquettaire débutant la coagulation sanguine.
Ce ne sont pas des cellules car elles ne contiennent pas de noyau, mais des fragments de cytoplasme provenant de leurs précurseurs, les mégacaryocytes (cellules géantes de la moelle osseuse).
Ces éléments figurés constituent 45 % du sang entier, ce sont toutes les cellules contenues dans le sang.
Les 55 % restants constituent le plasma sanguin, un liquide jaunâtre qui est la phase liquide et sert de suspension pour le sang.
- Hématies = 120 jours (production = 200 milliards/j)
- Neutrophiles = 1 – 3 jours (production = 50 milliards/j)
- Monocytes = quelques mois.
- Lymphocytes = quelques mois à plusieurs années
- Plaquettes = 7 – 10 jours (production = 100 milliards/j)
 |  |  | |
| Hématie (globule rouge) | Hématie (globule rouge) | Plaquettes | Lymphocyte |
 | |  | |
| PN | PE | PB | Monocyte |
Le plasma
Il est la composante liquide du sang dans laquelle baignent les éléments figurés; cependant il faut bien comprendre que les éléments figurés ne font pas partie du plasma.
Il est composé d’eau, ions, lipides, glucides, protides et facteurs de coagulation.

Bonjour, avez vous fait un rapport de stage sur les laboratoire d’analyses médicale?